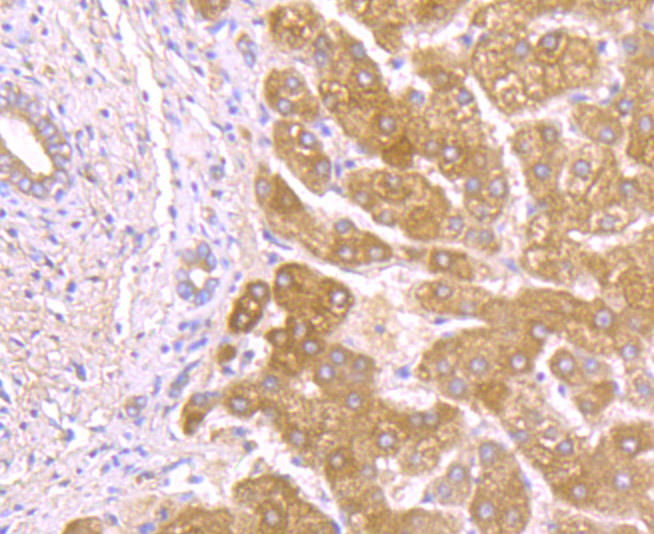

Catalog# ER1802-27
Alpha 1 Acid Glycoprotein Rabbit Polyclonal Antibody
Application
-
WB
-
IHC-P
-
FC
Reactivity
-
Human
-
Mouse
-
Rat